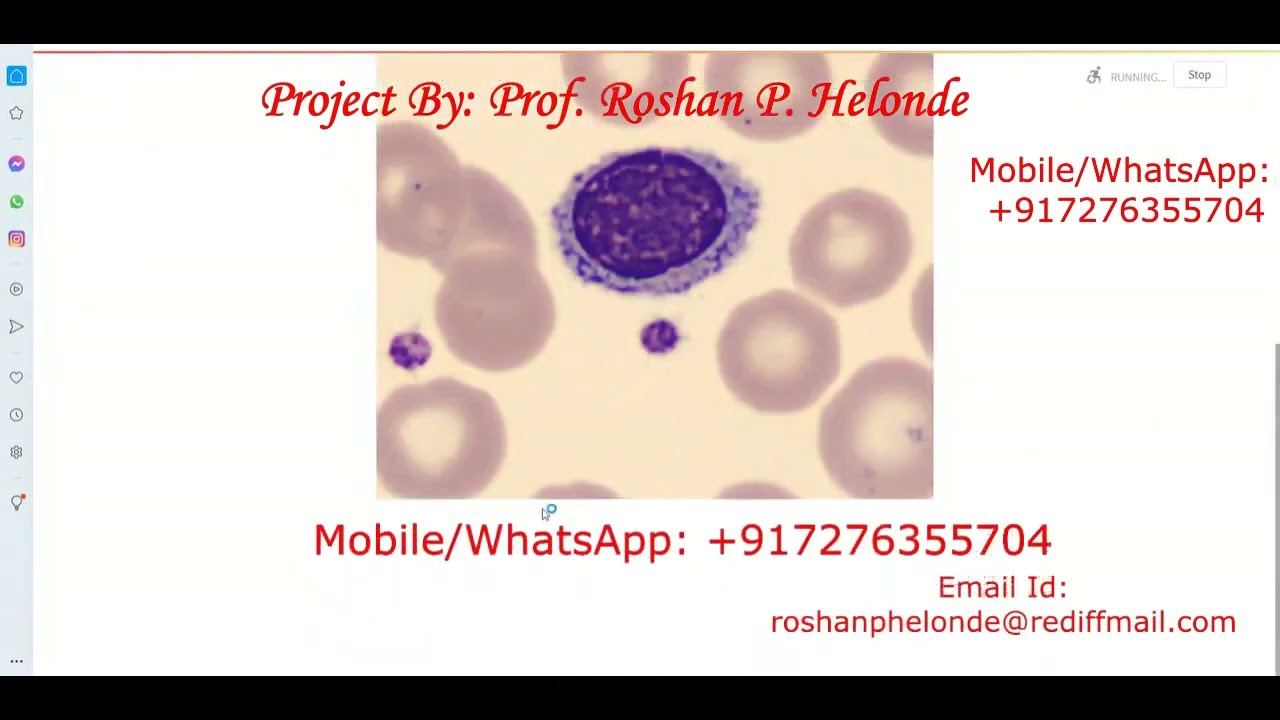
Blood Cell Classification with CNN in Python 🩸 | Neural Network Blood Cell Detection

Blood Cell Classification with CNN in Python 🩸 | Neural Network Blood Cell Detection
Discover how to classify blood cells using Convolutional Neural Networks with our Python source code. Subscribe for updates and download the complete project from our website!

Roshan Helonde
780 views • Feb 24, 2022
About this video
Subscribe to our channel to get this project directly on your email
Download this full project with Source Code from http://enggprojectworld.blogspot.com
http://matlabsproject.blogspot.com
https://lowpriceprojects.blogspot.com
https://matlabprojectcodes.blogspot.com
https://excellentprojectsolution.blogspot.com
Contact:
Prof. Roshan P. Helonde
Mobile: +91-7276355704
WhatsApp: +917276355704
Email: roshanphelonde@rediffmail.com
Liver Cancer Detection Using Matlab Source Code
https://bit.ly/3cU0Jh8
Real Time Face Recognition Using Matlab Source Code
https://bit.ly/3cVKJvg
Image Watermarking using Compression attack
https://bit.ly/3cVb9gA
DES Encryption Decryption Using Matlab Source Code
https://bit.ly/34m3nsh
Content Based Image Retrieval Using Matlab
https://bit.ly/3cSH1Cy
Vehicle License Number Plate Recogniton Using Matlab Source Code
https://bit.ly/3jwDlJe
Blood Cancer Detection Using Matlab Source Code
https://bit.ly/3juellP
https://bit.ly/3irXOO2
DCT Based Steganography Using Matlab Code
https://bit.ly/3l3J21I
RSA Encryption Decryption Using Matlab Code
https://bit.ly/3nfWOjB
Image Restoration Using Matlab Source Code
https://bit.ly/34izB7T
Prostate Cancer Detection Using Matlab Source Code
https://t.ly/qPhT
Shadow Detection and Removal Using Matlab Source Code
https://bit.ly/3iyl5Ow
Fruit Disease Detection Using Matlab Source Code
https://bit.ly/3jy1yPy
Barcode Recognition Using Matlab Source Code
https://bit.ly/3cUoR3d
Brain Tumor Detection using CNN
https://bit.ly/2Smletz
Melanoma Skin Cancer Detection Using Matlab Source Code
https://bit.ly/3nd87Jf
Image Inpainting Using Matlab Source Code
https://bit.ly/30tufWd
Bone Fracture Detection Using Matlab Source Code
https://t.ly/izek
Video Steganography Using Matlab Source Code
https://bit.ly/2GmLBNC
AES Encryption Using Matlab Source Code
https://bit.ly/3ngQ7hi
Iris Recognition Using Matlab Source Code
https://rb.gy/m9g6ue
Diabetic Retinopathy Detection using CNN Source Code
https://rb.gy/gwkz8q
Audio Steganography Using Python Source Code
https://bit.ly/2St8t08
Fake Currency Recognition Using Matlab Source Code
https://rb.gy/braldx
Skin Disease Detection Using Matlab Source Code
https://rb.gy/x3hvtf
DWT and DCT Based Image Watermarking Using Matlab Source Code
https://rb.gy/xsenxf
Currency Recognition Using Matlab Source Code
https://rb.gy/corvup
Handwritten Digit Recognition Using Matlab Source Code
https://rb.gy/1jguaf
Content Based Image Retrieval System using SVM Source Code
https://rb.gy/kyoenb
Blood Group Detection using Neural Network Source Code
https://rb.gy/go52qc
Fruit Disease Detection using Neural Network Source Code
https://rb.gy/1bgqgn
Lung Cancer Detection using Neural Network Source Code
https://rb.gy/ueeod1
Image Compression using DWT and DCT Source Code
https://rb.gy/xmpcj1
Rice Leaf Disease Detection Using Matlab Source Code
https://rb.gy/jogicw
Audio Steganography Using Matlab Hide Text in Audio Source Code
https://rb.gy/fdbhuo
Image Enhancement using Histogram Equalization Source Code
https://rb.gy/12rc6d
AES Steganography Using Matlab Source Code
https://rb.gy/npoans
Breast Cancer Detection using Neural Network Source Code
https://rb.gy/ejwobh
Audio Emotion Recognition Using Matlab
https://rb.gy/vz8w9z
Image Denoising Using Matlab
https://rb.gy/jq9y1u
RSA Based Steganography Using Matlab
https://rb.gy/todpnm
Traffic Sign Recognition using Python Source Code
https://cutt.ly/Zf7Au6f
Signature Recognition using Neural Network
https://cutt.ly/df7AoBI
Image Fusion using Wavelet Transform & PCA
https://cutt.ly/Lf7Ap2k
FingerNail Disease Detection Using Matlab
https://cutt.ly/Jf7Aank
Facial Expression Emotion Recognition Using Matlab
https://cutt.ly/Rf7AaNP
Mango Leaf Disease Detection Using Matlab
https://cutt.ly/4f7AsIC
Age and Gender Recognition using Python Source Code
https://cutt.ly/sf7Adeu
Audio Watermarking Using Matlab
https://cutt.ly/Qf7AdRD
RBC and WBC Detection Using Matlab
https://cutt.ly/df7Ad3J
Cheque Signature Recognition Using Matlab
https://cutt.ly/gf7Af9u
Devnagri/Marathi Charater Recogniton Using Matlab
https://cutt.ly/If7Agx1
Maize Leaf Disease Detection Using Matlab
https://cutt.ly/Pf7AgJb
Hand Gesture Recognition Using Matlab
https://cutt.ly/uf7Ag8p
Plant Disease Detection Using Matlab
https://cutt.ly/uf7Ahkc
Plant Disease Detection using Neural Network
https://cutt.ly/rf7Ajej
#enggprojectworld #matlabsproject #excellentprojectsolution
Matlab Projects, Image Processing Project topics, Final Year Project Topics, Matlab Project Topics, Electronics Engineering Project Topics,Computer Engineering Project Topics,How to Develop GUI in Matlab, Biomedical Engineering Project Topics, Matlab Source Code, How to Develop Matlab Project, How to Develop Image Processing Project, How to Develop GUI in Python, Python Project Code, Segmentation using kmean, Classification in Image Processing, Feature Extraction in Image Processing, Image Segmentation Code, Feature Extraction Code, Classification Code, IEEE Based Projects
Download this full project with Source Code from http://enggprojectworld.blogspot.com
http://matlabsproject.blogspot.com
https://lowpriceprojects.blogspot.com
https://matlabprojectcodes.blogspot.com
https://excellentprojectsolution.blogspot.com
Contact:
Prof. Roshan P. Helonde
Mobile: +91-7276355704
WhatsApp: +917276355704
Email: roshanphelonde@rediffmail.com
Liver Cancer Detection Using Matlab Source Code
https://bit.ly/3cU0Jh8
Real Time Face Recognition Using Matlab Source Code
https://bit.ly/3cVKJvg
Image Watermarking using Compression attack
https://bit.ly/3cVb9gA
DES Encryption Decryption Using Matlab Source Code
https://bit.ly/34m3nsh
Content Based Image Retrieval Using Matlab
https://bit.ly/3cSH1Cy
Vehicle License Number Plate Recogniton Using Matlab Source Code
https://bit.ly/3jwDlJe
Blood Cancer Detection Using Matlab Source Code
https://bit.ly/3juellP
https://bit.ly/3irXOO2
DCT Based Steganography Using Matlab Code
https://bit.ly/3l3J21I
RSA Encryption Decryption Using Matlab Code
https://bit.ly/3nfWOjB
Image Restoration Using Matlab Source Code
https://bit.ly/34izB7T
Prostate Cancer Detection Using Matlab Source Code
https://t.ly/qPhT
Shadow Detection and Removal Using Matlab Source Code
https://bit.ly/3iyl5Ow
Fruit Disease Detection Using Matlab Source Code
https://bit.ly/3jy1yPy
Barcode Recognition Using Matlab Source Code
https://bit.ly/3cUoR3d
Brain Tumor Detection using CNN
https://bit.ly/2Smletz
Melanoma Skin Cancer Detection Using Matlab Source Code
https://bit.ly/3nd87Jf
Image Inpainting Using Matlab Source Code
https://bit.ly/30tufWd
Bone Fracture Detection Using Matlab Source Code
https://t.ly/izek
Video Steganography Using Matlab Source Code
https://bit.ly/2GmLBNC
AES Encryption Using Matlab Source Code
https://bit.ly/3ngQ7hi
Iris Recognition Using Matlab Source Code
https://rb.gy/m9g6ue
Diabetic Retinopathy Detection using CNN Source Code
https://rb.gy/gwkz8q
Audio Steganography Using Python Source Code
https://bit.ly/2St8t08
Fake Currency Recognition Using Matlab Source Code
https://rb.gy/braldx
Skin Disease Detection Using Matlab Source Code
https://rb.gy/x3hvtf
DWT and DCT Based Image Watermarking Using Matlab Source Code
https://rb.gy/xsenxf
Currency Recognition Using Matlab Source Code
https://rb.gy/corvup
Handwritten Digit Recognition Using Matlab Source Code
https://rb.gy/1jguaf
Content Based Image Retrieval System using SVM Source Code
https://rb.gy/kyoenb
Blood Group Detection using Neural Network Source Code
https://rb.gy/go52qc
Fruit Disease Detection using Neural Network Source Code
https://rb.gy/1bgqgn
Lung Cancer Detection using Neural Network Source Code
https://rb.gy/ueeod1
Image Compression using DWT and DCT Source Code
https://rb.gy/xmpcj1
Rice Leaf Disease Detection Using Matlab Source Code
https://rb.gy/jogicw
Audio Steganography Using Matlab Hide Text in Audio Source Code
https://rb.gy/fdbhuo
Image Enhancement using Histogram Equalization Source Code
https://rb.gy/12rc6d
AES Steganography Using Matlab Source Code
https://rb.gy/npoans
Breast Cancer Detection using Neural Network Source Code
https://rb.gy/ejwobh
Audio Emotion Recognition Using Matlab
https://rb.gy/vz8w9z
Image Denoising Using Matlab
https://rb.gy/jq9y1u
RSA Based Steganography Using Matlab
https://rb.gy/todpnm
Traffic Sign Recognition using Python Source Code
https://cutt.ly/Zf7Au6f
Signature Recognition using Neural Network
https://cutt.ly/df7AoBI
Image Fusion using Wavelet Transform & PCA
https://cutt.ly/Lf7Ap2k
FingerNail Disease Detection Using Matlab
https://cutt.ly/Jf7Aank
Facial Expression Emotion Recognition Using Matlab
https://cutt.ly/Rf7AaNP
Mango Leaf Disease Detection Using Matlab
https://cutt.ly/4f7AsIC
Age and Gender Recognition using Python Source Code
https://cutt.ly/sf7Adeu
Audio Watermarking Using Matlab
https://cutt.ly/Qf7AdRD
RBC and WBC Detection Using Matlab
https://cutt.ly/df7Ad3J
Cheque Signature Recognition Using Matlab
https://cutt.ly/gf7Af9u
Devnagri/Marathi Charater Recogniton Using Matlab
https://cutt.ly/If7Agx1
Maize Leaf Disease Detection Using Matlab
https://cutt.ly/Pf7AgJb
Hand Gesture Recognition Using Matlab
https://cutt.ly/uf7Ag8p
Plant Disease Detection Using Matlab
https://cutt.ly/uf7Ahkc
Plant Disease Detection using Neural Network
https://cutt.ly/rf7Ajej
#enggprojectworld #matlabsproject #excellentprojectsolution
Matlab Projects, Image Processing Project topics, Final Year Project Topics, Matlab Project Topics, Electronics Engineering Project Topics,Computer Engineering Project Topics,How to Develop GUI in Matlab, Biomedical Engineering Project Topics, Matlab Source Code, How to Develop Matlab Project, How to Develop Image Processing Project, How to Develop GUI in Python, Python Project Code, Segmentation using kmean, Classification in Image Processing, Feature Extraction in Image Processing, Image Segmentation Code, Feature Extraction Code, Classification Code, IEEE Based Projects
Tags and Topics
Browse our collection to discover more content in these categories.
Video Information
Views
780
Likes
30
Duration
2:46
Published
Feb 24, 2022
Related Trending Topics
LIVE TRENDSRelated trending topics. Click any trend to explore more videos.